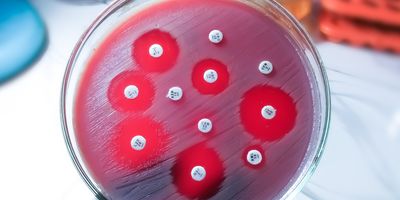
Antimicrobial susceptibility testing in petri dish.

Articles by The Peter Doherty Institute for Infection and Immunity
SARS-CoV-2 Able to Momentarily Accelerate Its Evolutionary Pace
The Peter Doherty Institute for Infection and Immunity
This acceleration in evolutionary pace could help explain the rapid emergence of new variants